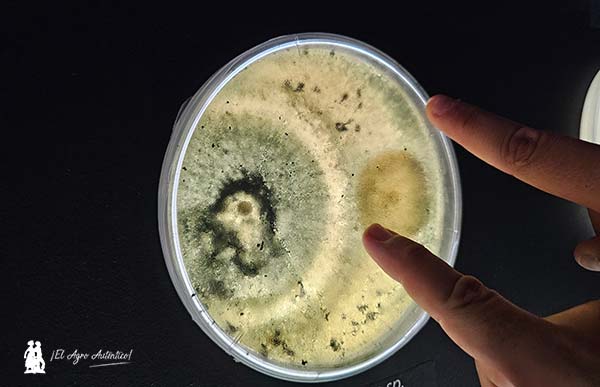

Tabla de Contenidos

Si buscamos en el origen de las cosas, el viaje es fascinante. Trichodex es una empresa biotecnológica, integrada hoy día en el Grupo Fertiberia, que en su mismo nombre lleva implícito como seña de identidad su origen: las trichodermas. Su eslogan es toda una declaración de intenciones: ‘Somos reyes del microbioma’ – ese universo de los microorganismos presente en toda forma de vida, desde el reino vegetal hasta los seres humanos – encuentra en Trichodex la ciencia necesaria para aprender sobre el origen de las cosas importantes de la vida.

El laboratorio viaja de Sevilla a Madrid
En un gran expositor del Grupo Fertiberia, asentado en el Pabellón 5 del Ifema de Madrid, Trichodex ha instalado esta semana en Fruit Attraction 2025 un laboratorio convertido en una huella imborrable de la vida sobre la Tierra. Los microorganismos están presentes en todo, desde la expresión de una huella humana cuando nos estrechamos la mano hasta cualquier porción de suelo que tomemos en un parque.
Y en este laboratorio, instalado en Sevilla pero que estos días atrás ha tenido su réplica en Madrid, ha quedado reflejada la impronta de la I+D+i de Trichodex con microorganismos en la tarea de encontrar soluciones biológicas a la fertilización, estimulación o protección de las plantas.

El origen de los formulados
Con el microbioma la agricultura puede ser más resiliente ante cualquier desafío actual y futuro. Junto a Khalid Akdi, director general de Trichodex; Ana Mª Ramírez, investigadora; y Daniel Jiménez, Global Market Development, nos adentramos en unos pocos metros a lo largo de un pasillo que cuenta millones de historias de microorganismos que están en la base de muchos de los formulados que se emplean hoy día en la agricultura.
Sin lugar a dudas este laboratorio portátil ha aportado un contenido de calidad y diferencial a la presencia del Grupo Fertiberia y Trichodex dando valor a un expositor que se ha convertido en uno de los más interesantes de cuantos hemos visitado en la edición 2025 de la feria agrícola de Madrid.
Colección de 1.500 especies
Con Khalid, Ana y Daniel hemos podido conocer en este laboratorio una pincelada de microorganismos procedentes de todo el planeta. Una selección de una colección que a su vez alcanza más de 1.500 especies de cepas distintas.
De origen muy variopintos, por ejemplo cepas de zonas del mundo en las que los microorganismos se han adaptado a temperaturas extremas. O aquellos que sobreviven al estrés salino que pueda provocar el ecosistema de unas Marinas. Solo dos ejemplos de decenas de ellos que abren la mente para entender por dónde va e irá la agricultura presente y venidera.


Microorganismos de Trichodex
Ana y Daniel nos han mostrado selecciones de hongos patógenos frente a otros beneficiosos. Y como cepa estrella su trichoderma adaptada a las diferentes condiciones, incluso a las más difíciles y complejas.
Resultado de toda esta investigación hay productos comerciales en el mercado como Bacnifos, a base de Pseudomonas sp, para mitigar el estrés salino. También está Vibacter, un consorcio de bacterias entre ellas Azobacter sp. para fijar nitrógeno y otras funciones, ya que crea un biofilm en la raíz que le permite interactuar con otros micororganismos obteniendo distintos beneficios para la planta.
Son solo dos ejemplos, el resto de herramientas comerciales, fruto de años de estudio sobre el microbioma están en la propia web de Trichodex (pinchar aquí).







